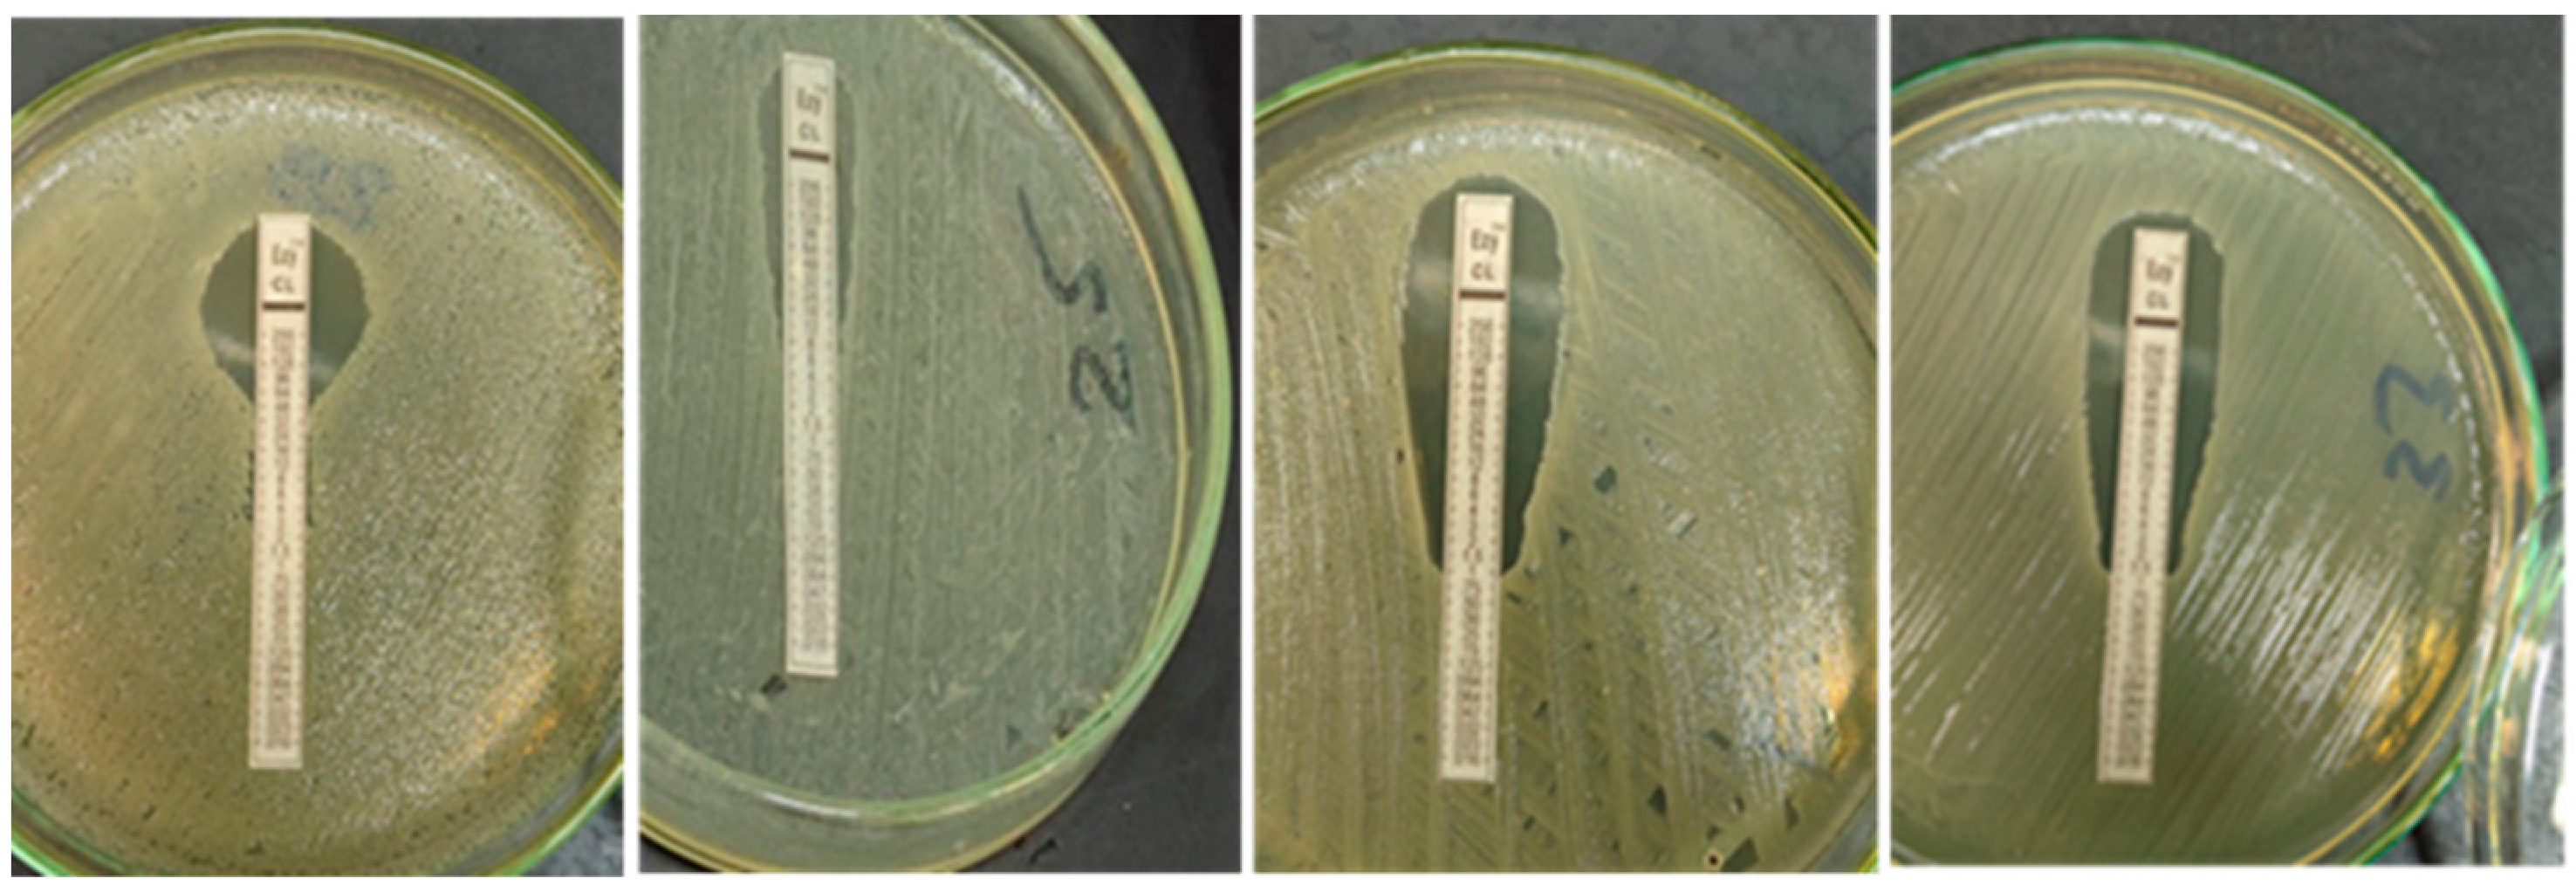
Vetsci 09 00282 g002

Phenotypic and Genotypic Screening of Colistin Resistance Associated with Emerging Pathogenic Escherichia coli Isolated from Poultry
Abstract
:1. Introduction
2. Material and Methods
2.1. Sample Collection
2.2. Isolation and Identification
2.3. Antimicrobial and Colistin Susceptability Patterns of E. coli Isolates
2.3.1. Antimicrobial Sensitivity Test (AST)
2.3.2. Assessment of Colistin Resistance by Chromogenic Medium
2.3.3. Quantitative Determination of Colistin Resistance (E-Test)
2.3.4. Quantitative Determination of Colistin by Minimum Inhibitory Concentration (MIC)
2.3.5. Genotypic Characterizations of Colistin Resistance of E. coli Isolates
3. Results
3.1. E. coli Isolation, Biochemical Characterization and Serotyping
3.2. Antimicrobial Senstivity Patterns of the Isolated E. coli
3.2.1. Antimicrobial Sensitivity Test (AST)
3.2.2. Growth on Chromogenic Medium
3.2.3. Quantitative Determination of Colistin Resistance MIC by E-Test
3.2.4. Confirmatory Quantitative Determination of Colistin Resistance MIC by Sensititre
3.2.5. Genotypic Characterizations of Colistin Resistance
4. Discussion
5. Conclusions
Author Contributions
Funding
Institutional Review Board Statement
Informed Consent Statement
Data Availability Statement
Acknowledgments
Conflicts of Interest
References
- Nolan, L.K.; Barnes, H.J.; Vaillancourt, J.P.; Abdul-Aziz, T.; Logue, C.M. Colibacillosis, 13th ed.; Wiley-Blackwell: Hoboken, NJ, USA, 2013. [Google Scholar]
- Hoelzer, K.; Wong, N.; Thomas, J.; Talkington, K.; Jungman, E.; Coukell, A. Antimicrobial drug use in food-producing animals and associated human health risks: What, and how strong, is the evidence? BMC Vet. Res. 2017, 13, 211. [Google Scholar] [CrossRef] [PubMed]
- Moawad, A.A.; Hotzel, H.; Neubauer, H.; Ehricht, R.; Monecke, S.; Tomaso, H.; Hafez, H.M.; Roesler, U.; El-Adawy, H. Antimicrobial resistance in Enterobacteriaceae from healthy broilers in Egypt: Emergence of colistin-resistant and extended-spectrum β-lactamase-producing Escherichia coli. Gut Pathog. 2018, 10, 39. [Google Scholar] [CrossRef] [PubMed] [Green Version]
- Biswas, S.; Brunel, J.M.; Dubus, J.C.; Reynaud-Gaubert, M.; Rolain, J.M. Colistin: An update on the antibiotic of the 21st century. Expert Rev. Anti Infect. Ther. 2012, 10, 917–934. [Google Scholar] [CrossRef] [PubMed]
- Paul, M.; Daikos, G.L.; Durante-Mangoni, E.; Yahav, D.; Carmeli, Y.; Benattar, Y.D.; Skiada, A.; Andini, R.; Eliakim-Raz, N.; Nutman, A.; et al. Colistin alone versus colistin plus meropenem for treatment of severe infections caused by carbapenem-resistant Gram-negative bacteria: An open-label, randomised controlled trial. Lancet Infect. Dis. 2018, 18, 391–400. [Google Scholar] [CrossRef]
- Velkov, T.; Thompson, P.E.; Nation, R.L.; Li, J. Structure-activity relationships of polymyxin antibiotics. J. Med. Chem. 2010, 53, 1898–1916. [Google Scholar] [CrossRef] [Green Version]
- Mendelson, M.; Brink, A.; Gouws, J.; Mbelle, N.; Naidoo, V.; Pople, T.; Schellack, N.; van Vuuren, M.; Rees, H. The One Health stewardship of colistin as an antibiotic of last resort for human health in South Africa. South African One Health Stewardship Sub-Committee of the Ministerial Advisory Committee on Antimicrobial Resistance. Lancet Infect. Dis. 2018, 18, e288–e294. [Google Scholar] [CrossRef]
- Osei Sekyere, J. Mcr colistin resistance gene: A systematic review of current diagnostics and detection methods. Microbiologyopen 2019, 8, e00682. [Google Scholar] [CrossRef] [Green Version]
- WHO. Manual for the Laboratory Identification and Antimicrobial Susceptibility Testing of Bacterial Pathogens of Public Health Importance in the Developing World; WHO: Geneva, Switzerland, 2003. [Google Scholar]
- CLSI. Performance Standards for Antimicrobial Susceptibility Testing; CLSI: Wayne, PA, USA, 2021. [Google Scholar]
- Liu, Y.Y.; Wang, Y.; Walsh, T.R.; Yi, L.X.; Zhang, R.; Spencer, J.; Yu, L.F. Emergence of plasmid-mediated colistin resistance mechanism mcr-1 in animals and human beings in China: A microbiological and molecular biological study. Lancet Infect. Dis. 2016, 16, 161–168. [Google Scholar] [CrossRef]
- Xavier, B.B.; Lammens, C.; Ruhal, R.; Kumar-Singh, S.; Butaye, P.; Goossens, H.; Malhotra-Kumar, S. Identification of a novel plasmid-mediated colistin-resistance gene, mcr-2, in Escherichia coli, Belgium, June 2016. Euro. Surveill. 2016, 21, 30280. [Google Scholar] [CrossRef]
- Yin, W.; Li, H.; Shen, Y.; Liu, Z.; Wang, S.; Shen, Z.; Wang, Y. Novel plasmid-mediated colistin resistance gene mcr-3 in Escherichia coli. mBio 2017, 8, e00543–e00617. [Google Scholar] [CrossRef] [Green Version]
- Carattoli, A.; Villa, L.; Feudi, C.; Curcio, L.; Orsini, S.; Luppi, A.; Magistrali, C.F. Novel plasmid-mediated colistin resistance mcr-4 gene in Salmonella and Escherichia coli, Italy 2013, Spain and Belgium, 2015 to 2016. Eurosurveillance 2017, 22, 30589. [Google Scholar] [CrossRef] [Green Version]
- Borowiak, M.; Fischer, J.; Hammerl, J.A.; Hendriksen, R.S.; Szabo, I.; Malorny, B. Identification of a novel transposon-associated phosphoethanolamine transferase gene, mcr-5, conferring colistin resistance in d-tartrate fermenting Salmonella enterica subsp. Enterica serovar Paratyphi B. J. Antimicrob. Chemother. 2017, 72, 3317–3324. [Google Scholar] [CrossRef] [Green Version]
- Lutful Kabir, S.M. Avian colibacillosis and salmonellosis: A closer look at epidemiology, pathogenesis, diagnosis, control and public health concerns. Int. J. Environ. Res. Public Health 2010, 7, 89–114. [Google Scholar] [CrossRef] [PubMed] [Green Version]
- Johnson, T.J.; Wannemuehler, Y.; Doetkott, C.; Johnson, S.J.; Rosenberger, S.C.; Nolan, L.K. Identification of minimal predictors of avian pathogenic Escherichia coli virulence for use as a rapid diagnostic tool. J. Clin. Microbiol. 2008, 46, 3987–3996. [Google Scholar] [CrossRef] [PubMed] [Green Version]
- Awad, A.M.; El-Shall, N.A.; Khalil, D.S.; Abd El-Hack, M.E.; Swelum, A.A.; Mahmoud, A.H.; Ebaid, H.; Komany, A.; Sammour, R.H.; Sedeik, M.E. Incidence, Pathotyping, and Antibiotic Susceptibility of Avian Pathogenic Escherichia coli among Diseased Broiler Chicks. Pathogens 2020, 9, 114. [Google Scholar] [CrossRef] [PubMed] [Green Version]
- Mohamed, L.; Ge, Z.; Yuehua, L.; Yubin, G.; Rachid, K.; Mustapha, O.; Junwei, W.; Karine, O. Virulence traits of avian pathogenic (APEC) and fecal (AFEC) E. coli isolated from broiler chickens in Algeria. Trop. Anim. Health Prod. 2018, 50, 547–553. [Google Scholar] [CrossRef]
- Azam, M.; Mohsin, M.; Sajjad-ur-Rahman; Muhammad, K.S. Virulence-associated genes and antimicrobial resistance among avian pathogenic Escherichia coli from colibacillosis affected broilers in Pakistan. Trop. Anim. Health Prod. 2019, 51, 1259–1265. [Google Scholar] [CrossRef]
- Elnagar, R.; Elkenany, R.; Younis, G. Interleukin gene expression in broiler chickens infected by different Escherichia coli serotypes. Vet. World 2021, 14, 2727–2734. [Google Scholar] [CrossRef]
- Ibrahim, R.A.; Cryer, T.L.; Lafi, S.Q.; Basha, E.A.; Good, L.; Tarazi, Y.H. Identification of Escherichia coli from broiler chickens in Jordan, their antimicrobial resistance, gene characterization and the associated risk factors. BMC Vet. Res. 2019, 15, 159. [Google Scholar] [CrossRef]
- Kathayat, D.; Lokesh, D.; Ranjit, S.; Rajashekara, G. Avian Pathogenic Escherichia coli (APEC): An Overview of Virulence and Pathogenesis Factors, Zoonotic Potential, and Control Strategies. Pathogens 2021, 10, 467. [Google Scholar] [CrossRef]
- Mellata, M. Human and avian extraintestinal pathogenic Escherichia coli: Infections, zoonotic risks, and antibiotic resistance trends. Foodborne Pathog. Dis. 2013, 10, 916–932. [Google Scholar] [CrossRef] [PubMed] [Green Version]
- Kim, Y.B.; Yoon, M.Y.; Ha, J.S.; Seo, K.W.; Noh, E.B.; Son, S.H.; Lee, Y.J. Molecular characterization of avian pathogenic Escherichia coli from broiler chickens with colibacillosis. Poult. Sci. 2020, 99, 1088–1095. [Google Scholar] [CrossRef] [PubMed]
- Rahman, M.M.; Husna, A.; Elshabrawy, H.A.; Alam, J.; Runa, N.Y.; Badruzzaman, A.T.M.; Banu, N.A.; Al Mamun, M.; Paul, B.; Das, S.; et al. Isolation and molecular characterization of multidrug-resistant Escherichia coli from chicken meat. Sci. Rep. 2020, 10, 21999. [Google Scholar] [CrossRef]
- Elsayed, M.S.A.E.; Eldsouky, S.M.; Roshdy, T. Genetic and antimicrobial resistance profiles of non-O157 Shiga toxin-producing Escherichia coli from different sources in Egypt. BMC Microbiol. 2021, 21, 257. [Google Scholar] [CrossRef]
- Abdul Momin, M.H.F.; Bean, D.C.; Hendriksen, R.S.; Haenni, M.; Phee, L.M.; Wareham, D.W. CHROMagar COL-APSE: A selective bacterial culture medium for the isolation and differentiation of colistin-resistant Gram-negative pathogens. J. Med. Microbiol. 2017, 66, 1554–1561. [Google Scholar] [CrossRef] [PubMed]
- Jahantigh, M.; Dizaji, R.E. Antimicrobial drug resistance pattern of Escherichia coli isolated from chickens farms with colibacillosis infection. Open J. Med. Microbiol. 2015, 5, 159–162. [Google Scholar] [CrossRef] [Green Version]
- Matuschek, E.; Åhman, J.; Webster, C.; Kahlmeter, G. Antimicrobial susceptibility testing of colistin—Evaluation of seven commercial MIC products against standard broth microdilution for Escherichia coli, Klebsiella pneumoniae, Pseudomonas aeruginosa, and Acinetobacter spp. Clin. Microbiol. Infect. 2018, 24, 865–870. [Google Scholar] [CrossRef] [Green Version]
- Kansak, N.; Aslan, M.; Adaleti, R.; Aksaray, S. Evaluation of the Two Commercial Methods Based on Broth Microdilution Against Reference Microdilution Method for Klebsiella pneumoniae Isolates. Mikrobiyol. Bul. 2020, 54, 606–612. [Google Scholar] [CrossRef]
- Lima, B.N.; Nielsen, D.W.; Wannemuehler, Y.; Cavender, T.; Hussein, A.; Yan, S. mcr-1 identified in Avian Pathogenic Escherichia coli (APEC). PLoS ONE 2017, 12, e0172997. [Google Scholar]
- Chabou, S.; Leulmi, H.; Rolain, J.M. Emergence of mcr-1-mediated colistin resistance in Escherichia coli isolates from poultry in Algeria. J. Glob. Antimicrob. Resist. 2019, 16, 115–116. [Google Scholar] [CrossRef]
- Rahmatallah, N.; El Rhaffouli, H.; Laraqui, A. Detection of colistin encoding resistance genes MCR-1 in isolates recovered from broiler chickens in Morocco. Saudi J. Pathol. Microbiol. 2018, 3, 520–521. [Google Scholar]
- Grami, R.; Mansour, W.; Mehri, W.; Bouallègue, O.; Boujaâfar, N.; Madec, J.Y.; Haenni, M. Impact of food animal trade on the spread of mcr-1-mediated colistin resistance, Tunisia, July 2015. Eurosurveillance 2016, 21, 30144. [Google Scholar] [CrossRef] [PubMed]
- Chabou, S.; Leangapichart, T.; Okdah, L.; Le Page, S.; Hadjadj, L.; Rolain, J.M. Real-time quantitative PCR assay with Taqman(®) probe for rapid detection of MCR-1 plasmid-mediated colistin resistance. New Microbes New Infect. 2016, 13, 71–74. [Google Scholar] [CrossRef] [PubMed] [Green Version]
- Bernasconi, O.J.; Principe, L.; Tinguely, R.; Karczmarek, A.; Perreten, V.; Luzzaro, F.; Endimiani, A. Evaluation of a new commercial microarray platform for the simultaneous detection of beta-lactamase and mcr-1 and mcr-2 genes in enterobacteriaceae. J. Clin. Microbiol. 2017, 55, 3138–3141. [Google Scholar] [CrossRef] [PubMed] [Green Version]
- Shen, Y.; Wu, Z.; Wang, Y.; Zhang, R.; Zhou, H.W.; Wang, S.; Lei, L. Heterogeneous and flexible transmission of mcr-1 in Hospital-Associated Escherichia coli. MBio 2018, 9, e00943-e18. [Google Scholar] [CrossRef] [Green Version]
- Anyanwu, M.U.; Okpala, C.O.R.; Chah, K.F.; Shoyinka, V.S. Prevalence and Traits of Mobile Colistin Resistance Gene Harbouring Isolates from Different Ecosystems in Africa. Biomed. Res. Int. 2021, 22, 6630379. [Google Scholar] [CrossRef]
- Bardet, L.; Bardet, L.; Page, S.L.; Leangapichart, T.; Rolain, J. LBJMR medium: A new polyvalent culture medium for isolating and selecting vancomycin and colistin-resistant bacteria. BMC Microbiol. 2017, 17, 220. [Google Scholar] [CrossRef] [Green Version]

| Target Gene | Primers Sequences | Amplified Segment (bp) | Amplification (35 Cycles) | Final Extension | Reference | ||
|---|---|---|---|---|---|---|---|
| Secondary Denaturation | Annealing | Extension | |||||
| mcr-1 | CGGTCAGTCCGTTTGTTC | 309 | 94 °C 30 s | 55 °C 30 s | 72 °C 30 s | 72 °C 10 min | [11] |
| CTTGGTCGGTCTGTAGGG | |||||||
| mcr-2 | TGGTACAGCCCCTTTATT | 1617 | 94 °C 30 s | 55 °C 40 s | 72 °C 1.2 min | 72 °C 12 min | [12] |
| GCTTGAGATTGGGTTATGA | |||||||
| mcr-3 | TTGGCACTGTATTTTGCATTT | 542 | 94 °C 30 s | 50 °C 40 s | 72 °C 45 s | 72 °C 10 min | [13] |
| TTAACGAAATTGGCTGGAACA | |||||||
| mcr-4 | ATTGGGATAGTCGCCTTTTT | 487 | 94 °C 30 s | 54 °C 40 s | 72 °C 45 s | 72 °C 10 min | [14] |
| TTACAGCCAGAATCATTATCA | |||||||
| mcr-5 | ATGCGGTTGTCTGCATTTATC | 1644 | 94 °C 30 s | 50 °C 40 s | 72 °C 1.2 min | 72 °C 12 min | [15] |
| TCATTGTGGTTGTCCTTTTCTG | |||||||
| Antimicrobial Agent | E. coli (56) Poultry Isolates | ||
|---|---|---|---|
| Resistant No. (%) * | Intermediate No. (%) * | Sensitive No. (%) * | |
| Ampicillin (AMP10) | 52 (92.9%) | 4 (7.1%) | 0 (0%) |
| Apramycin (APR30) | 40 (71.4%) | 7 (12.5%) | 9 (16.1%) |
| Ciprofloxacin (CIP5) | 37 (66.1%) | 7 (12.5%) | 12 (21.4%) |
| Clindamycin (DA2) | 56 (100%) | 0 (0%) | 0 (0%) |
| Colistin Sulphate (CT10) | 23 (41.1%) | 0 (0%) | 33 (58.9%) |
| Norfloxacin (NOR10) | 37 (66.1%) | 4 (7.1%) | 15 (26.8%) |
| Spectinomycin (SPT100) | 31 (55.2%) | 0 (0%) | 25 (44.6%) |
| Streptomycin (S10) | 54 (96.4%) | 0 (0%) | 2 (3.6%) |
| Sulfamethoxazole–Trimethoprim (SXT25) | 46 (82.1%) | 1 (1.8%) | 9 (16.1%) |
| Tetracycline (T30) | 56 (100%) | 0 (0%) | 0 (0%) |
| Code No. | E-Test (µg/mL) | Interpretation | Sensititre (µg/mL) | Interpretation |
|---|---|---|---|---|
| 1 | 1 | S | ≤0.25 | S |
| 2 | 4 | R | =2 | S |
| 3 | 1 | S | ≤0.25 | S |
| 4 | 2 | S | =2 | S |
| 5 | 1 | S | ≤0.25 | S |
| 6 | 4 | R | =4 | R |
| 7 | 1.5 | S | ≤0.25 | S |
| 8 | 1 | S | ≤0.25 | S |
| 9 | 4 | R | ˃4 | R |
| 10 | 1 | S | =0.5 | S |
| 11 | 1.5 | S | ≤0.25 | S |
| 12 | 1.5 | S | ≤0.25 | S |
| 13 | 1 | S | ≤0.25 | S |
| 14 | 1 | S | ≤0.25 | S |
| 15 | 4 | R | =4 | R |
| 16 | 1 | S | =0.5 | S |
| 17 | 2 | S | =2 | S |
| 18 | 0.75 | S | ≤0.25 | S |
| 19 | 0.75 | S | =1 | S |
| 20 | 4 | R | ˃4 | R |
Publisher’s Note: MDPI stays neutral with regard to jurisdictional claims in published maps and institutional affiliations. |
© 2022 by the authors. Licensee MDPI, Basel, Switzerland. This article is an open access article distributed under the terms and conditions of the Creative Commons Attribution (CC BY) license (https://creativecommons.org/licenses/by/4.0/).
Share and Cite
Badr, H.; Samir, A.; El-Tokhi, E.I.; Shahein, M.A.; Rady, F.M.; Hakim, A.S.; Fouad, E.A.; El-Sady, E.F.; Ali, S.F. Phenotypic and Genotypic Screening of Colistin Resistance Associated with Emerging Pathogenic Escherichia coli Isolated from Poultry. Vet. Sci. 2022, 9, 282. https://doi.org/10.3390/vetsci9060282
Badr H, Samir A, El-Tokhi EI, Shahein MA, Rady FM, Hakim AS, Fouad EA, El-Sady EF, Ali SF. Phenotypic and Genotypic Screening of Colistin Resistance Associated with Emerging Pathogenic Escherichia coli Isolated from Poultry. Veterinary Sciences. 2022; 9(6):282. https://doi.org/10.3390/vetsci9060282
Chicago/Turabian StyleBadr, Heba, Abdelhafez Samir, Essam Ismail El-Tokhi, Momtaz A. Shahein, Flourage M. Rady, Ashraf S. Hakim, Ehab Ali Fouad, Engy Farahat El-Sady, and Samah F. Ali. 2022. "Phenotypic and Genotypic Screening of Colistin Resistance Associated with Emerging Pathogenic Escherichia coli Isolated from Poultry" Veterinary Sciences 9, no. 6: 282. https://doi.org/10.3390/vetsci9060282
APA StyleBadr, H., Samir, A., El-Tokhi, E. I., Shahein, M. A., Rady, F. M., Hakim, A. S., Fouad, E. A., El-Sady, E. F., & Ali, S. F. (2022). Phenotypic and Genotypic Screening of Colistin Resistance Associated with Emerging Pathogenic Escherichia coli Isolated from Poultry. Veterinary Sciences, 9(6), 282. https://doi.org/10.3390/vetsci9060282








